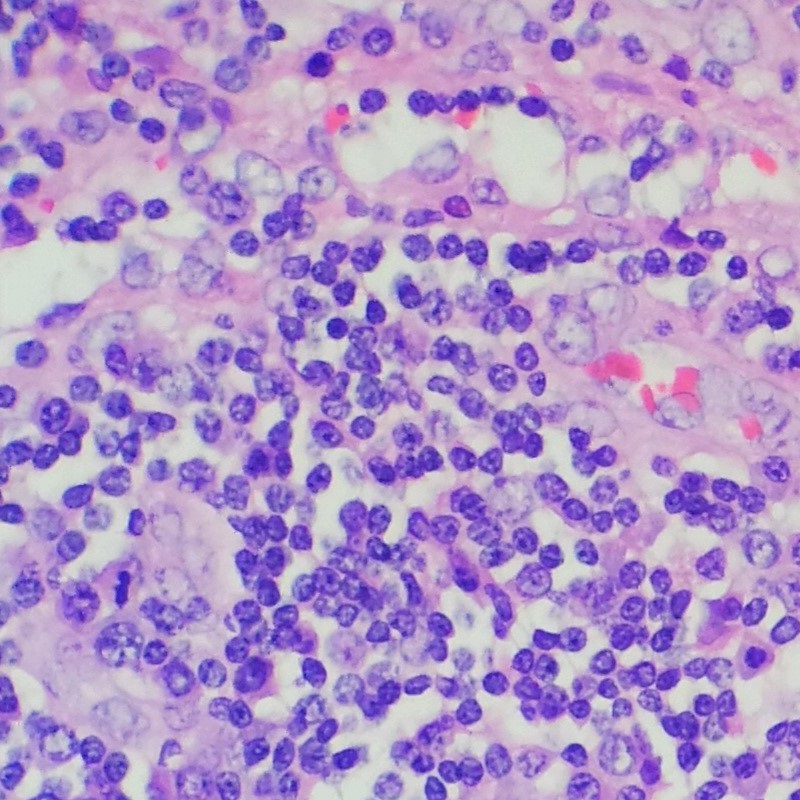

北京清华长庚医院病理科(作者:李勇、杨江辉)大家都知道警察办案需要证据,例如指纹、血迹、遗留的DNA痕迹等,进而对其进行分析推断与指控,而病理诊断亦是对患者身上取下来的标本进行分析,包括皮肤肿物、胃镜活检、内脏器官切除等临床手术后的送检组织。病理报告之所以被称为疾病诊断的“金标准”,是因为其犹如警察办案直击证据本源,通过观察组织细胞的形态学变化,从而一锤定音,明确疾病诊断,为临床大夫对疾病治疗、预后评估、症状解释提供准确依据。如此重要的病理报告是怎样诞生的?其中又有哪些相关问题需要我们知晓呢?让我们一起来了解一下......
一、病理报告的诞生过程
1.标本收件:收到标本后,病理科工作人员需要将标本与申请单信息进行逐一核实,包括患者的姓名、年龄、病历号、标本内容、标本数量、标本固定状态等,确认无误后将通过电脑系统创建绝对不变且唯一的病理编号,并将收件过程发现的问题标本进行退件。所谓“失之毫厘,谬以千里”,信息的核对在病理科全流程工作中都不可或缺,标本收件也是病理科质量控制的第一道关口。
2.标本固定和取材:固定是将标本放在10%中性福尔马林液中,以起到保留组织形态结构、细胞内成分的功能。固定不充分将会给后续的制片和诊断工作带来很多困难,通常情况下固定时间少则4~6小时,多则12~24小时。固定后病理医生要对标本进行取材,即选取病变有代表性的部位将其切成合适的大小,并将取材过程中对标本的文字描述信息录入电脑。
3.脱水、透明和浸蜡处理:现在绝大数医院病理科都已配备全自动脱水机,可以根据实际使用需求对取材后组织设定相关十几道的试剂处理程序。通俗来讲,脱水机程序是将组织在10%中性福尔马林中固定、在梯度酒精里进行脱水、在二甲苯中进行透明并最后将组织在石蜡中浸透。此操作的目的是将组织中细胞的水分置换出来,然后再把石蜡注入细胞内,使处理后的标本将能够符合后续制片要求,总耗时约12小时左右。
4.包埋、切片、染色和封片:包埋是指将浸蜡后组织放入包埋的模具中,经过石蜡与组织的冷却融合,做成组织蜡块。切片是将组织蜡块在切片机上切成厚3-5微米的组织蜡片,并贴在载玻片上,其后经过烤片机烘烤,使组织粘附在载玻片上。切片后的组织因其没有颜色,无法在显微镜下辨别细胞的形态结构,需要将切片经过十几道试剂的处理来完成染色,包括脱蜡、脱苯和常规苏木素-伊红(HE)染色等,耗时约1个小时左右。染色后的切片,细胞中不同成分会染成不同的颜色,滴上中性树胶并盖上盖玻片进行封片后就完成了制片的整个操作。目前包埋及切片步骤为病理技师手工操作,染色及封片步骤可用相应自动化机器完成,制作后的切片可供病理医师在显微镜下进行观察。


(注:左侧为包埋后的组织蜡块,右侧为蜡块与其制备完成后的切片对比)
医生阅片:病理医师将染色后切片在显微镜下观察,通过组织细胞的形态学变化对送检标本做出相应病理诊断。阅片通常分两级阅片,需由病理科住院医师和主治医师承担,然后经过报告上的双签字确认,得出最终诊断结果。由于可以在显微镜放大下分辨1微米水平的细胞变化,所以病理诊断是目前公认的对疾病最可信赖的定性诊断,是B超、CT、生化等手段所不能代替的。

(注:病理医师在显微镜低倍与高倍镜下观察到的两张不同病理切片的图像)
二、关于病理报告的问与答
1.问:病理报告究竟多久可以取到?
答:综上,报告诞生过程中的标本固定、脱水程序处理、医生阅片等步骤是无法跳过的,时间上是不可节省的。病理报告自送检之日开始算起,通常3~5个工作日发出。但如果常规染色无法满足诊断的需求,医生还会加开特染、免疫组织化学染色、FISH荧光原位杂交、基因检测等实验,通过不同水平及层次的实验来帮助疾病诊断。开展新实验后,报告日期在之前的3~5个工作日上短则延长几日,长则延长半个月左右。为了保证诊断的正确性,需要耐心等待,具体发出时间可以咨询病理科工作人员。
2.问:病理报告拿到手后应该如何解读?
答:病理报告中有大量的医学诊断用词,且疾病的分类十分复杂,后续的治疗也不尽相同,如果拿到报告后仅凭病患自己判断,可能会发生解读错误。另外病理报告中有时会出现考虑为、符合、不除外、建议等字眼,这更代表了疾病诊断的复杂性。所以我们建议拿到病理报告后应跟临床科室大夫进一步沟通和确认,保证后续诊疗的正确性,而不是自我过度解读,以免耽误病情的诊断与治疗。
3.问:手术送检的标本病理科会保存么?能保存多久?
答:首先送检标本会由病理医师按照取材规范选择病变部位和可疑部位取材,最后将其作成蜡块和染色切片,而这些蜡块和切片都是会长期保存的,是病理科最重要的资料。切片与蜡块长期保存的目的是方便病人后续会诊和进一步实验的需要,在发现问题时亦可以进行再度核查。至于病理医师取材后所剩余的日常活检标本原则上自病理诊断报告签发后保存2-4周,尸体解剖标本则保存3个月。


(注:病理技师制作完成的待观察切片与蜡块切片长期存放的保存柜)
4.问:为何新就诊医院的大夫会让我去借之前的病理切片进行会诊?
答:每个医院的临床医师会根据本院病理科的会诊意见进行治疗,在一些疑难疾病的判断及鉴别时,不同的病理大夫可能会有不同的诊断意见,有时病理报告上也会写出建议送至外院进行会诊。这时我们需要按照病理科切片借阅流程将切片借出,并连同诊断报告一起送至专科医院的病理科进行会诊。会诊后将会得到一份会诊报告,有助于疾病诊断的再次确认,从而提高后续治疗的准确性。
病理报告是病理科所有人员的劳动结晶,体现了病理医生和技师一丝不苟、严格要求的工作作风。当拿到病理报告后,应妥善保存并将结果与临床大夫进行沟通,正确发挥病理报告的作用,为后续临床的治疗及评估提供准确依据!

北京清华长庚医院APP
快速挂号